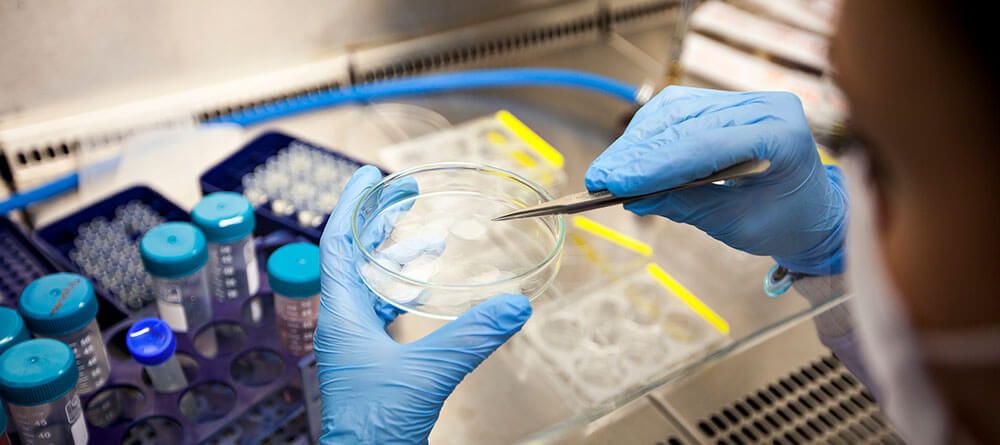

Working in pathology is a fitting path for physicians who are interested in uncovering answers to difficult medical questions. Assisting in the diagnosis, treatment, and study of diseases, these highly trained professionals will typically specialize in one of the many different types of pathology.
One of the more unique subspecialties in the field is forensic pathology. It is a branch of anatomic pathology in which physicians evaluate cases of sudden, unexpected, suspicious, and violent death by performing medicolegal autopsies. These specialists play a critical, behind-the-scenes role in medical cases of all kinds.
But what does a forensic pathologist do, exactly?
5 Commonly asked questions about forensic pathology
Forensic pathologists are specially trained physicians who examine the bodies of individuals who died suddenly, unexpectedly, or violently. Their expertise enables them to perform autopsies, investigate suspicious deaths, and ultimately determine how and by what means a person died.
Consider the following frequently asked questions about working as a forensic pathologist:

1. When are forensic autopsies performed?
Forensic pathologists don’t perform autopsies for every death that comes through the coroner’s office. The coroner, medical examiner, or Justice of the Peace has authority over cases of sudden, unexpected, violent, or traumatic death, and may order a forensic autopsy for further investigation. They may also take jurisdiction over cases involving a natural death under certain circumstances, ordering autopsies for further analysis.
If the deceased individual has a documented medical history that informs the circumstances surrounding their death, however, the forensic pathologist will typically release the case without performing an autopsy.
Additionally, a deceased person’s legal next of kin may also request an autopsy in cases where the medical examiner has not ordered one. Reasons for doing so can include the following:
- To uncover information about inheritable diseases or conditions
- If medical malpractice or medical neglect is suspected
- If there are potential insurance issues that an autopsy might resolve
2. What do forensic pathologists look for?
The primary goal of a forensic pathologist is to determine how and by what means a person died. In order to do this, the specialist must look for both a cause of death and a manner of death.
Cause of death is the underlying medical condition, disease, or injury that began the fatal chain of events resulting in death. Examples of possible causes of death include the following:
- Bronchopneumonia due to influenza A respiratory infection
- Posttraumatic seizure disorder due to blunt injury of the head
- Gastrointestinal hemorrhage due to cirrhosis of the liver
- Anoxic brain injury due to an acute fentanyl and cocaine intoxication
Manner of death, on the other hand, focuses on the way in which a death occurs. Most jurisdictions have five legally recognized manners of death:
- Homicide
- Suicide
- Accident
- Natural causes
- Undetermined
3. What does a forensic pathologist do to determine a cause and manner of death?
To establish the cause and manner of a death, forensic pathologists must collect critical details through a number of different methods. This process can involve some of the following duties:
- Studying the deceased person’s medical history
- Evaluating crime scene evidence, including witness statements
- Performing a medical autopsy
- Collecting medical and trace evidence for further analysis
In some cases, the specialists will even conduct onsite investigations, traveling to the scene of a death to collect data, evidence, and information pertaining to the case. Clinical forensic pathologists will also examine living patients—typically in cases where sexual assault or abuse is suspected.
This range of responsibilities requires a particular skill set. These physicians must maintain an expertise in toxicology, firearms/ballistics, trace evidence, blood analysis, DNA technology, and more.
Once all the evidence for a case has been collected and analyzed, the forensic pathologist will prepare a written report. They may also be called to testify to these findings in court. For that reason, specialists must be able to maintain a strong sense of confidence—they may be tasked with defending their conclusions in the face of opposition.
4. Where do forensic pathologists work?
Many physicians who specialize in forensic pathology work for city, county, or federal government agencies. A city, county, or state will typically appoint a forensic pathologist to act as medical examiner, coroner, or Justice of the Peace. Others work in hospitals, at medical schools, or with a private or group practice.
Regardless of employer, forensic pathologists spend most of their time working in a lab environment, performing autopsies or examining tissue samples. This can involve long days on their feet, working in the presence of often gruesome evidentiary conditions.
These specialists will work in tandem with a small group of other pathologists to help law enforcement and medical facilities understand the various circumstances surrounding a death. In addition to lab work, forensic pathologists may also commute to crime scene locations (as mentioned above) and/or be called upon to testify in a courtroom environment.

5. How do you become a forensic pathologist?
The first step to becoming a forensic pathologist is completing medical school. Once you earn your Doctor of Medicine (MD) degree, you’ll need to secure a four-year residency in general pathology. Your residency is when you’ll experience some of the most important hands-on training in your journey to becoming a physician, so it’s important to work hard to land the medical residency you want.
Once you complete your residency, you’ll then need to participate in 1-2 years of specialized training in a forensic pathology fellowship—after which you’ll become eligible for board certification as a forensic pathologist.
Pursue a career in forensic pathology
Now that you have a clear picture of what a forensic pathologist does, you can focus your energy on laying the groundwork you’ll need to become one. As you focus on completing your med school prerequisites, you should also be doing some research to help you find a program that will effectively prepare you for your future in forensic pathology.
You can learn more about the criteria you should be looking for in our article “How to Choose a Medical School: 8 Things to Evaluate Before Accepting.”

